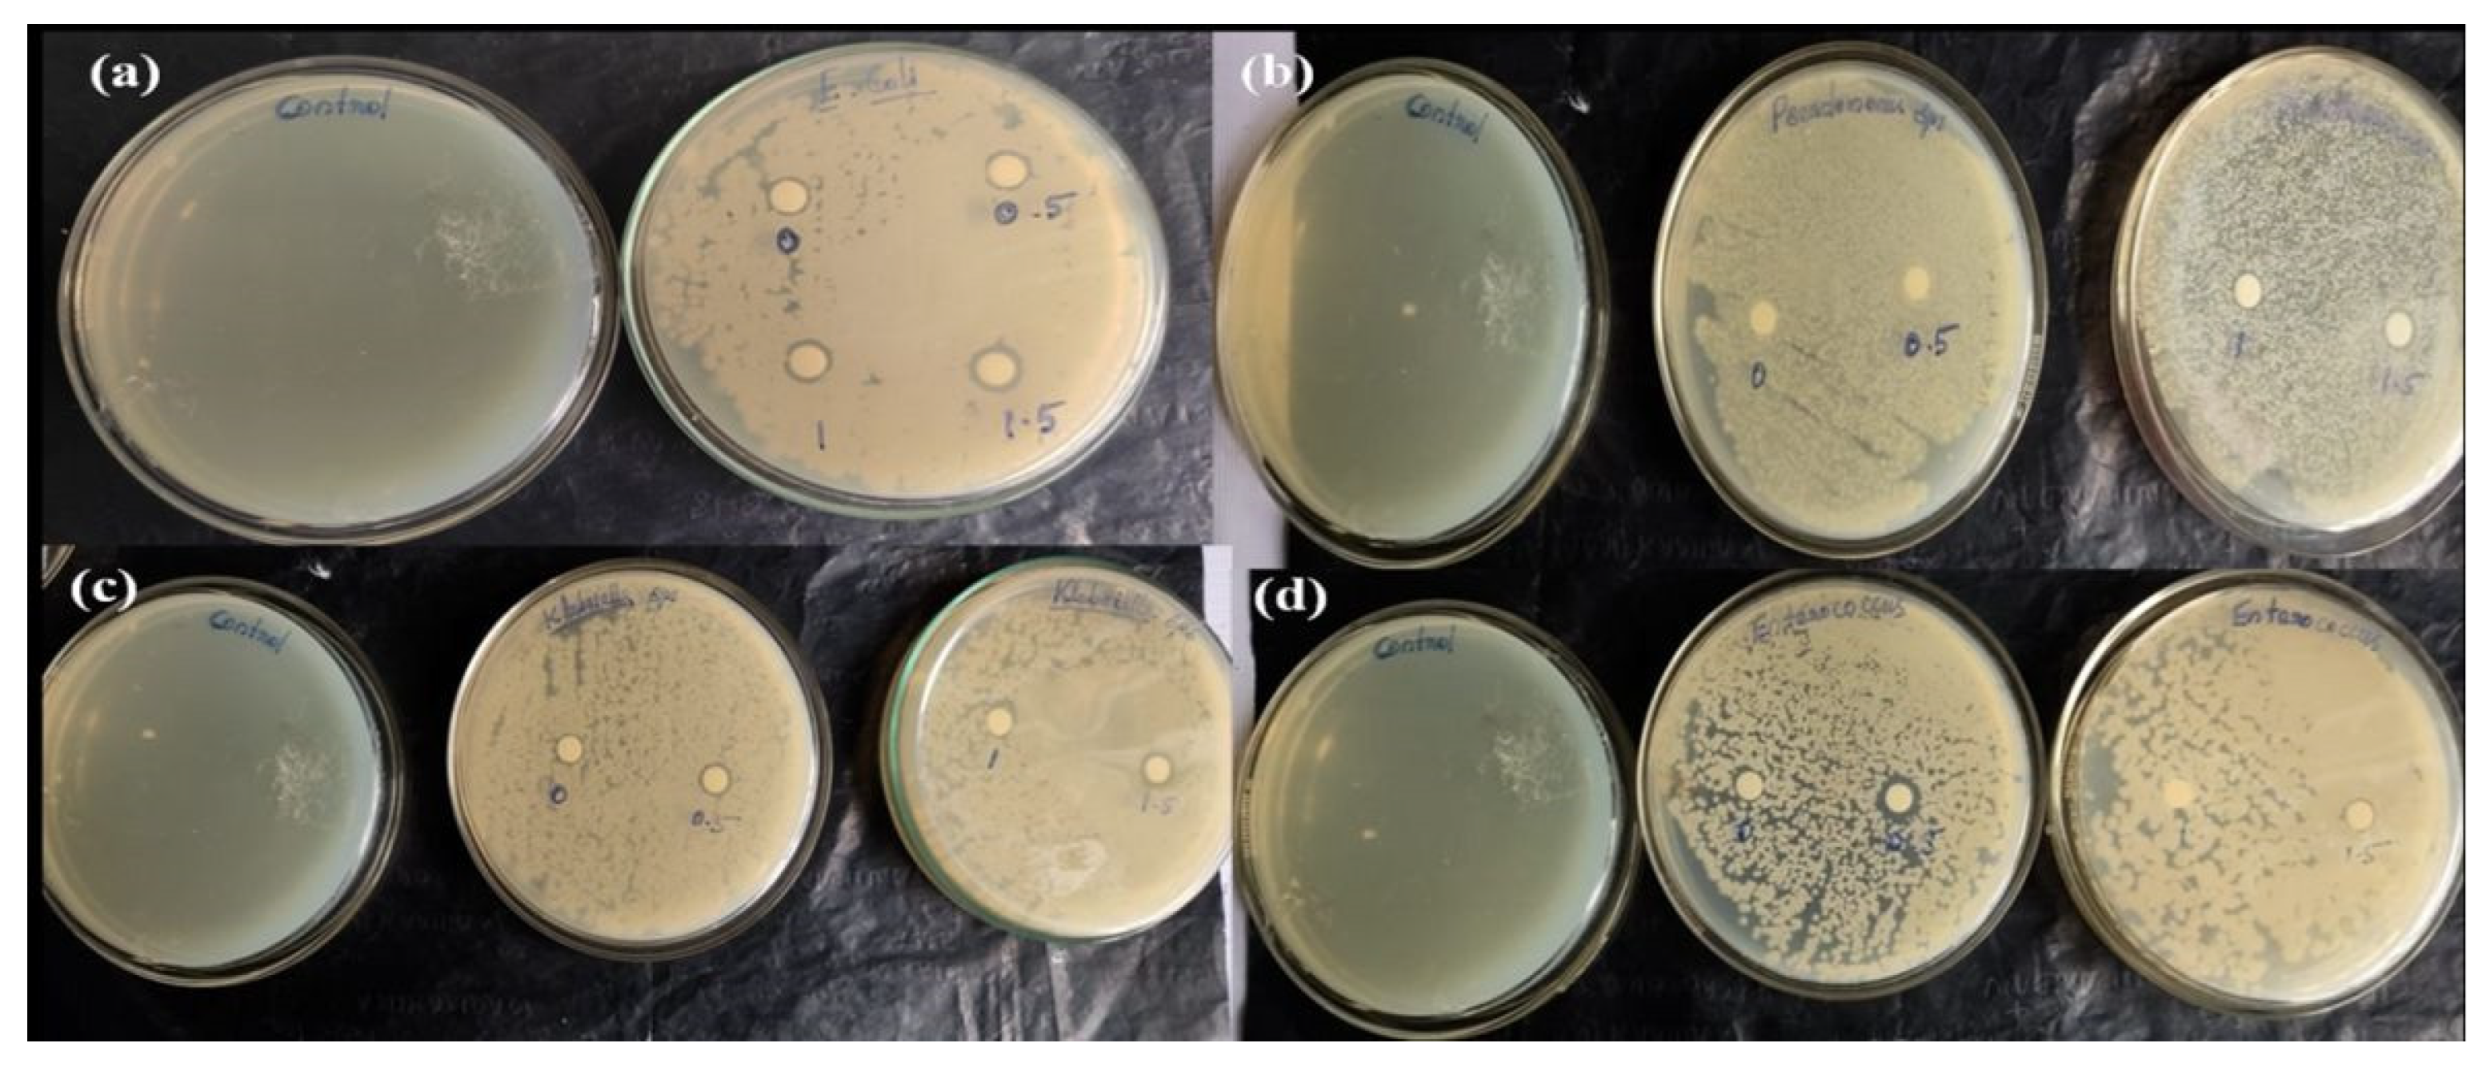
Processes 13 00229 g012

Chitosan/Polyvinyl Alcohol/g-C3N4 Nanocomposite Film: An Efficient Visible Light-Responsive Photocatalyst and Antimicrobial Agent
Abstract
1. Introduction
2. Materials and Methods
2.1. Chemicals
2.2. Synthesis of g-C3N4
2.3. Preparation of CS/PVA and CS/PVA/g-C3N4 Composite Films
2.4. Characterization
2.5. Visible-Light Photocatalytic Activity
2.6. Antimicrobial Activity
3. Results and Discussion
3.1. XRD Analysis
3.2. FE-SEM and Elemental Mapping Analysis
3.3. FT-IR Analysis
3.4. Differential Scanning Calorimetry
3.5. Thermogravimetric Analysis
3.6. UV–Visible Spectroscopy Analysis
3.7. Photocatalytic Activity
3.8. Effect of pH
3.9. Regeneration and Reusability of the Catalyst
3.10. Antibacterial Activity
4. Conclusions
Supplementary Materials
Author Contributions
Funding
Data Availability Statement
Acknowledgments
Conflicts of Interest
References
- Arif, A.; Malik, M.F.; Liaqat, S.; Aslam, A.; Mumtaz, K.; Afzal, A.; Ch, D.M.; Nisa, K.; Khurshid, F.; Arif, F.; et al. Water pollution and industries. Pure Appl. Biol. 2020, 9, 2214–2224. [Google Scholar] [CrossRef]
- Madhav, S.; Ahamad, A.; Singh, A.K.; Kushawaha, J.; Chauhan, J.S.; Sharma, S.; Singh, P. Water Pollutants: Sources and Impact on the Environment and Human Health Advanced Functional Materials and Sensors. In Sensors in Water Pollutants Monitoring: Role of Material. Advanced Functional Materials and Sensors; Pooja, D., Kumar, P., Singh, P., Patil, S., Eds.; Springer: Singapore, 2019. [Google Scholar] [CrossRef]
- Alsukaibi, A.K.D. Various Approaches for the Detoxification of Toxic Dyes in Wastewater. Processes 2022, 10, 1968. [Google Scholar] [CrossRef]
- Saravanan, A.; Senthil Kumar, P.; Jeevanantham, S.; Karishma, S.; Tajsabreen, B.; Yaashikaa, R.P.; Reshma, B. Effective water/wastewater treatment methodologies for toxic pollutants removal: Processes and applications towards sustainable Development. Chemosphere 2021, 280, 130595. [Google Scholar] [CrossRef] [PubMed]
- Crini, G.; Lichtfouse, E. Advantages and disadvantages of techniques used for wastewater treatment. Environ. Chem. Lett. 2019, 17, 145–155. [Google Scholar] [CrossRef]
- Hanafi, M.F.; Sapawe, N. A review on the current techniques and technologies of organic pollutants removal from water/wastewater. Mater. Today Proc. 2020, 31, A158–A165. [Google Scholar] [CrossRef]
- Wang, X.; Fang, W.; Yan, D.; Han, D.; Liu, J.; Ren, Z.; Ouyang, C.; Li, Y.; Wang, Q.; Cao, A. Evaluation of the influence of temperature and relative humidity on the permeability of four films to the fumigant dimethyl disulfide. J. Environ. Manag. 2019, 236, 687–694. [Google Scholar] [CrossRef]
- Indumathi, M.P.; Saral Sarojini, K.; Rajarajeswari, G.R. Antimicrobial and biodegradable chitosan/cellulose acetate phthalate/ZnO nano composite films with optimal oxygen permeability and hydrophobicity for extending the shelf life of black grape fruits. Int. J. Biol. Macromol. 2019, 132, 1112–1120. [Google Scholar] [CrossRef]
- Flórez, M.; Guerra-Rodríguez, E.; Cazón, P.; Vázquez, M. Chitosan for food packaging: Recent advances in active and intelligent films. Food Hydrocoll. 2022, 124, 107328. [Google Scholar] [CrossRef]
- Liu, S.; Gao, X.; Fan, H.; Zhang, M.; Geoffrey, I.N.; Waterhouse, G.I.N.; Zhu, S. Green and recyclable graphitic carbon nitride/chitosan/polyvinyl alcohol photocatalytic films with efficient antibacterial activity for fruit packing. Int. J. Biol. Macromol. 2023, 236, 123974. [Google Scholar] [CrossRef]
- Nwabor, O.F.; Singh, S.; Paosen, S.; Vongkamjan, K.; Voravuthikunchai, S.P. Enhancement of food shelf life with polyvinyl alcohol-chitosan nanocomposite films from bioactive Eucalyptus leaf extracts. Food Biosci. 2020, 36, 100609. [Google Scholar] [CrossRef]
- Yang, D.; Liu, Q.; Gao, Y.; Wan, S.; Meng, F.; Weng, W.; Zhang, Y. Characterization of silver nanoparticles loaded chitosan/polyvinyl alcohol antibacterial films for food packaging. Food Hydrocoll. 2023, 136, 108305. [Google Scholar] [CrossRef]
- Chauhan, A.; Negi, A.; Kashyap, R.; Sharma, B.; Sharma, R.K.; Chaudhary, G.R. Cellulose/chitosan/g-C3N4 nano-architectured films for visible light induced photocatalytic removal of methylene blue and Cr (VI) from water. Ind. Crops Prod. 2023, 202, 117113. [Google Scholar] [CrossRef]
- Shaida, M.F.; Verma, S.; Talukdar, S.; Kumar, N.; Mahtab, M.S.; Naushad, M.U.; Farooqi, I.H. Critical analysis of the role of various iron-based heterogeneous catalysts for advanced oxidation processes: A state of the art review. J. Mol. Liq. 2023, 374, 121259. [Google Scholar] [CrossRef]
- Pandis, P.K.; Kalogirou, C.; Kanellou, E.; Vaitsis, C.; Savvidou, M.G.; Sourkouni, G.; Zorpas, A.A.; Argirusis, C. Key Points of Advanced Oxidation Processes (AOPs) for Wastewater, Organic Pollutants and Pharmaceutical Waste Treatment: A Mini Review. ChemEngineering 2022, 6, 8. [Google Scholar] [CrossRef]
- Fdez-Sanroman, A.; Pazos, M.; Rosales, E.; Sanroman, A. Pushing the Operational Barriers for g-C3N4: A Comprehensive Review of Cutting-Edge Immobilization Strategies. Catalysts 2024, 14, 175. [Google Scholar] [CrossRef]
- Ahmadmoazzam, M.; Akbari, H.; Adibzadeh, A.; Pourfadakari, S.; Akbari, H. Visible-light-driven TiO2@Fe2O3/Chitosan nanocomposite with promoted photodegradation of meropenem and imipenem antibiotics by peroxymonosulfate. Environ. Technol. Int. J. Biol. Macromol. 2024, 45, 3456–3467. [Google Scholar] [CrossRef]
- Gupta, N.M. Factors affecting the efficiency of a water splitting photocatalyst: A Perspective. Renew. Sustain. Energy Rev. 2017, 71, 585–601. [Google Scholar] [CrossRef]
- Mukherjee, D.; Bruggen, B.V.; Mandal, B. Advancements in visible light responsive MOF composites for photocatalytic decontamination of textile wastewater: A review. Chemosphere 2022, 295, 133835. [Google Scholar] [CrossRef]
- Truong, H.B.; Bae, S.; Cho, J.; Hur, J. Advances in application of g–C3N4–based materials for treatment of polluted water and wastewater via activation of oxidants and photoelectrocatalysis: A comprehensive review. Chemosphere 2022, 286, 13173. [Google Scholar] [CrossRef]
- Li, Y.; Li, X.; Zhanga, H.; Xianga, Q. Porous graphitic carbon nitride for solar photocatalytic applications. Nanoscale Horiz. 2020, 5, 765–786. [Google Scholar] [CrossRef]
- Li, Y.; Gu, M.; Zhang, X.; Fan, J.; Lv, K.; Carabineiro, S.A.C.; Dong, F. 2D g-C3N4 for advancement of photo generated carrier dynamics status and challenges. Mater. Today 2020, 41, 270–303. [Google Scholar] [CrossRef]
- Rubi, R.V.C.; Olay, J.G.; Caleon, P.B.G.; De Jesus, R.A.F.; Indab, M.B.L.; Jacinto, R.C.H.; Sabalones, M.S.; Rosa, F.D.; Hamidah, N.L. Photocatalytic Degradation of Diazinon in g-C3N4/Fe(III)/persulfate system under Visible LED Light Irradiation. Appl. Sci. Eng. Prog. 2021, 14, 100–107. [Google Scholar] [CrossRef]
- Ahmed, M.A.; Mahmoud, S.A.; Mohamed, A.A. Unveiling the photocatalytic potential of graphitic carbon nitride (g-C3N4): A state-of-the-art review. RSC Adv. 2024, 14, 25629–25662. [Google Scholar] [CrossRef] [PubMed]
- Soni, S.; Teli, S.; Teli, P.; Agarwal, S. Empowering sustainability: Charting the seven years of progress in g-C3N4 based materialsand their crucial role in building a greener future. Sustain. Chem. Pharm. 2024, 41, 101693. [Google Scholar] [CrossRef]
- Santiago-Ramírez, C.R.; Nair, P.R.; Vela-Monroy, C.A.; Aba-Guevara, C.G.; Ramos-Delgado, N.A.; Gracia-Pinilla, M.A. A Mini review on the use of g-C3N4–Chitosan Biocomposite for Potential Applications. Front. Mater. 2022, 9, 856350. [Google Scholar] [CrossRef]
- Thurston, J.H.; Clifford, A.J.; Henderson, B.S.; Smith, T.R.; Quintana, D.; Cudworth, K.F.; Lujan, T.J.; Cornell, K.A. Development of Photoactive g-C3N4/Poly(vinyl alcohol) Composite Hydrogel Films with Antimicrobial and Antibiofilm Activity. ACS Appl. Bio. Mater. 2020, 3, 1681–1689. [Google Scholar] [CrossRef]
- Wang, J.; Li, M.; Zhou, S.; Xue, A.; Zhang, Y.; Zhao, Y.; Zhong, J.; Zhang, Q. Graphitic carbon nitride nanosheets embedded in poly(vinyl alcohol) nanocomposite membranes for ethanol dehydration via pervaporation. Sep. Purif. Technol. 2017, 188, 24–37. [Google Scholar] [CrossRef]
- Ni, Y.; Shi, S.; Li, M.; Zhang, L.; Yang, C.; Du, T.; Wang, S.; Nie, H.; Sun, J.; Zhang, W.; et al. Visible light responsive, self-activated bionanocomposite films with sustained antimicrobial activity for food packaging. Food Chem. 2021, 362, 130201. [Google Scholar] [CrossRef]
- Liu, C.; Ling, J.; Yang, L.-Y.; Ouyang, X.-K.; Wang, N. Chitosan-based carbon nitride-polydopamine-silver composite dressing with antibacterial properties for wound healing. Carbohydr. Polym. 2023, 303, 120436. [Google Scholar] [CrossRef]
- Ahmed, A.; Niazi, M.B.K.; Jahan, Z.; Samin, G.; Pervaiz, E.; Hussain, A.; Mehran, M.T. Enhancing the Thermal, Mechanical and Swelling Properties of PVA/Starch Nanocomposite Membranes Incorporating g-C3N4. J. Polym. Environ. 2020, 28, 100–115. [Google Scholar] [CrossRef]
- Bai, X.; Luan, J.; Song, T.; Sun, H.; Dai, Y.; Yu, J.; Tian, H. Chitosan-Grafted Carbon Oxynitride Nanoparticles: Investigation of Photocatalytic Degradation and Antibacterial Activity. Polymers 2023, 15, 1688. [Google Scholar] [CrossRef] [PubMed]
- Monika, M.; Rahman, A.F.M.; Salem, K.S.; Bari, M.D.L.; Qiu, H. Architecting Ultrathin Graphitic C3N4 Nanosheets Incorporated PVA/Gelatin Bionanocomposite for Potential Biomedical Application: Effect on Drug Delivery, Release Kinetics, and Antibacterial Activity. ACS Appl. Bio Mater. 2022, 5, 5126–5139. [Google Scholar] [CrossRef]
- Zheng, X.; Zheng, H.; Xiong, Z.; Zhao, R.; Liu, Y.; Zhao, C.; Zheng, C. Novel Anionic polyacrylamide-modify-chitosan Magnetic Composite Nanoparticles with Excellent Adsorption Capacity for Cationic Dyes and pH-independent Adsorption Capability for Metal Ions. Chem. Eng. J. 2020, 392, 123706. [Google Scholar] [CrossRef]
- Khairy, M.; Abdelrahman, E.A.; Taha, K.K.; Ismail, M.; Modwi, A. Facile synthesis of highly active ZrO2-MgO@g-C3N4 nanostructures for efficient removal of Cd (II) ions: Adsorption mechanism. Diam. Relat. Mater. 2024, 141, 110681. [Google Scholar] [CrossRef]
- Zhao, C.; Yan, Q.; Wang, S.; Dong, P.; Zhang, L. Regenerable g-C3N4–chitosan beads with enhanced photocatalytic activity and stability. RSC Adv. 2018, 8, 27516–27524. [Google Scholar] [CrossRef]
- Ahmed, M.A.; Mohamed, A.A. The use of chitosan-based composites for environmental remediation: A review. Int. J. Biol. Macromol. 2023, 242, 124787. [Google Scholar] [CrossRef]
- Ke, C.-L.; Deng, F.-S.; Chuang, C.-Y.; Lin, C.-H. Antimicrobial Actions and Applications of Chitosan. Polymers 2021, 13, 904. [Google Scholar] [CrossRef]
- Lian, R.; Cao, J.; Jiang, X.; Rogachev, A.V. Prolonged release of ciprofloxacin hydrochloride from chitosan/gelatin/poly (vinyl alcohol) composite films. Mater. Today Commun. 2021, 27, 102219. [Google Scholar] [CrossRef]
- Jo, W.-K.; Natarajan, T.S. Influence of TiO2 morphology on the photocatalytic efficiency of direct Z-scheme g-C3N4/TiO2 photocatalysts for isoniazid degradation. Chem. Eng. J. 2015, 281, 549–565. [Google Scholar] [CrossRef]
- He, S.; Wang, J.; Yu, M.; Xue, Y.; Hu, J.; Lin, J. Structure and Mechanical Performance of Poly(vinyl Alcohol) Nanocomposite by Incorporating Graphitic Carbon Nitride Nanosheets. Polymers 2019, 11, 610. [Google Scholar] [CrossRef]
- Kumar, S.; Krishnakumar, B.; Sobral, A.J.F.N.; Koh, J. Bio-based (Chitosan/PVA/ZnO) nanocomposites film: Thermally stable and photoluminescence material for removal of organic dye. Carbohydr. Polym. 2018, 205, 559–564. [Google Scholar] [CrossRef]
- Yan, S.C.; Li, Z.S.; Zou, Z.G. Photodegradation Performance of g-C3N4 Fabricated by Directly Heating Melamine. Langmuir 2009, 25, 10397–10401. [Google Scholar] [CrossRef]
- Voronova, M.I.; Surov, O.V.; Guseinov, S.S.; Barannikov, V.P.; Zakharov, A.G. Thermal stability of polyvinyl alcohol/nanocrystalline cellulose composites. Carbohydr. Polym. 2015, 130, 440–447. [Google Scholar] [CrossRef]
- Songa, R.; Xuea, R.; Hea, L.H.; Liua, Y.; Xiaoba, Q.L. The structure and properties of chitosan/poly ethylene glycol/silica ternary hybrid organic-inorganic films. Chin. J. Polym. Sci. 2008, 26, 621–630. [Google Scholar] [CrossRef]
- Wang, Z.; Zheng, L.; Li, C.; Zhanga, D.; Xiaoa, Y.; Guana, G.; Zhu, W. Modification of chitosan with monomethyl fumaric acid in anionic liquid solution. Carbohydr. Polym. 2015, 117, 973–979. [Google Scholar] [CrossRef]
- Li, J.; Zhang, X.; Li, X.; Duan, L.; Yang, X.; Wang, L.; Lu, W. Highly transparent and flexible graphitic C3N4 nanowire/PVA/PEDOT:PSS supercapacitors for transparent electronic devices. Funct. Mater. Lett. 2020, 13, 2051006. [Google Scholar] [CrossRef]
- Aslam, M.; Raza, Z.A.; Siddique, A. Fabrication and chemo-physical characterization of CuO/chitosan nanocomposite-mediated tricomponent PVA films. Polym. Bull. 2021, 78, 1955–1965. [Google Scholar] [CrossRef]
- Olvera Bernal, R.A.; Olekhnovich, R.O.; Uspenskaya, M.V. Chitosan/PVA Nanofibers as Potential Material for the Development of Soft Actuators. Polymers 2023, 15, 2037. [Google Scholar] [CrossRef]
- Vigneshwaran, S.; Preethi, J.; Meenakshi, S. Removal of chlorpyrifos, an insecticide using metal free heterogeneous graphitic carbon nitride (g-C3N4) incorporated chitosan as catalyst: Photocatalytic and adsorption studies. Int. J. Biol.-Macromol. 2019, 132, 289–299. [Google Scholar] [CrossRef]
- Gholipour, A.; Bahrami, K.S.H.; Nouri, M. Chitosan-poly(vinyl alcohol) blend nanofibers: Morphology, biological and antimicrobial properties. e-Polym. 2009, 9, 1580–1591. [Google Scholar] [CrossRef]
- Tripathi, S.; Mehrotra, G.K.; Dutta, P.K. Physicochemical and bioactivity of crosslinked chitosan–PVA film for food packaging applications. Int. J. Biol.-Macromol. 2009, 45, 372–376. [Google Scholar] [CrossRef] [PubMed]
- Cay, A.; Miraftab, M.; Kumbasar, E.P.A. Characterization and swelling performance of physically stabilized electrospun poly(vinyl alcohol)/chitosan nanofibers. Eur. Polym. J. 2014, 61, 253–262. [Google Scholar] [CrossRef]
- Menaze, A.A.; Ismail, A.M.; Awwa, N.S.; Ibrahium, H. A Physical characterization and antibacterial activity of PVA/Chitosan matrix doped by selenium nanoparticles prepared via one-pot laser ablation route. J. Mater. Res. Technol. 2020, 9, 9598–9606. [Google Scholar] [CrossRef]
- Taher, M.A.; Elsherbiny, E.A. Impact of Isonicotinic Acid Blending in Chitosan/Polyvinyl Alcohol on Ripening-Dependent Changes of Green Stage Tomato. Polymers 2023, 15, 825. [Google Scholar] [CrossRef]
- Balakrishnan, A.; Chinthala, M.; Polagani, R.K. 3D kaolinite/g-C3N4-alginate beads as an affordable and sustainable photocatalyst for wastewater remediation. Carbohydr. Polym. 2024, 323, 121420. [Google Scholar] [CrossRef]
- Yadav, A.; Kang, S.W.; Hunge, Y.M. Photocatalytic degradation of Rhodamine B using graphitic carbon nitride photocatalyst. J. Mater. Sci. Mater. Electron. 2021, 32, 15577–15585. [Google Scholar] [CrossRef]
- Hunge, Y.M.; Yadav, A.A.; Mahadik, M.A.; Bulakhe, R.N.; Shim, J.J.; Mathe, V.L.; Bhosale, C.H. Degradation of organic dyes using spray deposited nanocrystalline stratified WO3/TiO2 photoelectrodes under sunlight illumination. Opt. Mater. 2018, 76, 260–270. [Google Scholar] [CrossRef]
- Milosevic, K.; Loncarevic, D.; Krusic, M.K.; Hadnadev-Kostic, M.; Dostanic, J. Eco-Friendly g-C3N4/Carboxymethyl Cellulose/Alginate Composite Hydrogels for Simultaneous Photocatalytic Degradation of Organic Dye Pollutants. Int. J. Mol. Sci. 2024, 25, 7896. [Google Scholar] [CrossRef]
- Chen, Y.; Ma, D.; He, G.; Pan, S. Effects of pH on the Photocatalytic Activity and Degradation Mechanism of Rhodamine B over Fusiform Bi Photocatalysts under Visible Light. Water 2024, 16, 2389. [Google Scholar] [CrossRef]
- Shi, Y.; Luo, L.; Zhang, Y.; Chen, Y.; Wang, S.; Li, L.; Long, Y.; Jiang, F. Synthesis and characterization of α/β-Bi2O3 with enhanced photocatalytic activity for 17α-ethynylestradiol. Ceram. Int. 2017, 43, 7627–7635. [Google Scholar] [CrossRef]
- Goswami, J.; Basyach, P.; Purkayastha, S.K.; Guha, A.K.; Hazarika, P.; Saikia, L. Boosting the photodegradation of rhodamine B with the CuWO4/g-C3N4 heterojunction by introducing biomass derived N-CQDs as an electron mediator: Mechanism and DFT calculations. New J. Chem. 2023, 47, 22304–22319. [Google Scholar] [CrossRef]
- Cui, Y.; Ding, Z.; Liu, P.; Antonietti, M.; Fua, X.; Wang, X. Metal-free activation of H2O2 by g-C3N4 under visible light irradiation for the degradation of organic pollutants. Phys. Chem. Chem. Phys. 2012, 14, 1455–1462. [Google Scholar] [CrossRef]
- Das, B.; Devi, M.; Deb, S.; Dhar, S.S. Boosting photocatalytic property of graphitic carbon nitride with metal complex fabrication for efficient degradation of organic pollutants. Chemosphere 2023, 323, 138230. [Google Scholar] [CrossRef]
- Beegum, S.A.; David, S.B. Synthesis and Antibacterial Study of Silver Nanoparticles-Nitrogen Doped Graphene Oxide-Chitosan Nanocomposite. Orient. J. Chem. 2023, 39, 154–160. [Google Scholar] [CrossRef]
- Fan, B.; Yang, D.; Feng, Q.; He, Y.; He, W.; Huang, M. Functional Polyvinyl Alcohol/Chitosan/C-AgNP/Starch Composite Gel with Excellent Swelling and Water Retention Properties for Effective Antibacterial Action. Processes 2024, 12, 2068. [Google Scholar] [CrossRef]

| Pathogenic Bacteria | CS/PVA (mm) | CS/PVA (0.5) g-C3N4 (mm) | CS/PVA (1) g-C3N4 (mm) | CS/PVA (1.5) g-C3N4 (mm) |
|---|---|---|---|---|
| E. coli | - | 10 | 11 | 11.5 |
| Pseudomonas sps. | - | 10 | 10.5 | 11 |
| Klebsiella sps. | 5 | 10 | 11 | 11.5 |
| Enterococcus sps. | 5 | 6 | - | 10 |
Disclaimer/Publisher’s Note: The statements, opinions and data contained in all publications are solely those of the individual author(s) and contributor(s) and not of MDPI and/or the editor(s). MDPI and/or the editor(s) disclaim responsibility for any injury to people or property resulting from any ideas, methods, instructions or products referred to in the content. |
© 2025 by the authors. Licensee MDPI, Basel, Switzerland. This article is an open access article distributed under the terms and conditions of the Creative Commons Attribution (CC BY) license (https://creativecommons.org/licenses/by/4.0/).
Share and Cite
Sutharsan, M.; Senthil Murugan, K.; Narayanan, K.; Natarajan, T.S. Chitosan/Polyvinyl Alcohol/g-C3N4 Nanocomposite Film: An Efficient Visible Light-Responsive Photocatalyst and Antimicrobial Agent. Processes 2025, 13, 229. https://doi.org/10.3390/pr13010229
Sutharsan M, Senthil Murugan K, Narayanan K, Natarajan TS. Chitosan/Polyvinyl Alcohol/g-C3N4 Nanocomposite Film: An Efficient Visible Light-Responsive Photocatalyst and Antimicrobial Agent. Processes. 2025; 13(1):229. https://doi.org/10.3390/pr13010229
Chicago/Turabian StyleSutharsan, Murugan, Krishnan Senthil Murugan, Kanagaraj Narayanan, and Thillai Sivakumar Natarajan. 2025. "Chitosan/Polyvinyl Alcohol/g-C3N4 Nanocomposite Film: An Efficient Visible Light-Responsive Photocatalyst and Antimicrobial Agent" Processes 13, no. 1: 229. https://doi.org/10.3390/pr13010229
APA StyleSutharsan, M., Senthil Murugan, K., Narayanan, K., & Natarajan, T. S. (2025). Chitosan/Polyvinyl Alcohol/g-C3N4 Nanocomposite Film: An Efficient Visible Light-Responsive Photocatalyst and Antimicrobial Agent. Processes, 13(1), 229. https://doi.org/10.3390/pr13010229

